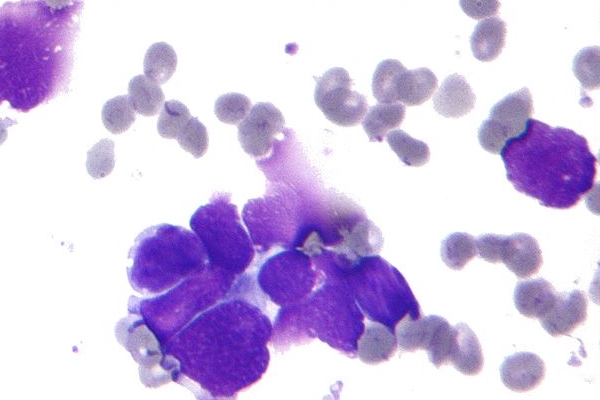

신라젠은 2006년 3월에 설립된 회사로, 2016년 12월에 코스닥에 상장한 면역 항암 연구 개발 중소기업입니다. 대표는 문은상으로 현재 미공개 주식 정보를 이용해 손실을 줄인 혐의로 조사를 받고 있으며 현재 신라젠은 거래중지 중입니다.
신라젠 사건을 얘기해보자면 우선 알아야 할 게 항암제입니다. 항암제는 1세대, 2세대, 3세대가 존재합니다. 1세대 항암제는 정상세포와 암세포의 구분 없이 빨리 분열하는 세포를 공격함으로써 우리 몸에서 빨리 분열하는 정자와 머리카락 등이 같이 공격받아 불임이 되거나, 머리카락이 빠지는 등의 심각한 부작용이 발생합니다.
2세대 항암제는 특정 암세포만 공격하는 항암제로 표적항암제라고 불립니다. 특정 암세포만 공격하기 때문에 1세대 항암제에 비해 부작용이 많이 줄었습니다. 그럼 3세대는 어떨까요? 면역항암제라고도 불리우는 3세대 항암제는 정상세포로 위장한 암세포의 위장을 벗겨내 몸의 면역기능이 암세포를 공격하게 만듭니다. 부작용도 적고 대부분의 암에 효과적입니다.

여기서 펙사벡이 등장하는데 미국의 데이빗 H. 컨이라는 과학자가 천연두 백신인 우두바이러스를 이용해 3세대 항암제를 만든다고 하는데 이게 바로 펙사벡입니다. 이 아이디어를 낸 데이빗 H. 컨은 제너렉스라는 회사를 만들어 돈을 벌려고 합니다. 펙사벡이라는 아이디어에 감명을 받은 한국의 황태호 박사는 지인들과 돈을 모아 제너렉스에 20억을 투자하게 됩니다.
이때가 2006년으로 동아대 창업지원센터에 제너렉스 하청회사를 세우고 신라젠이라고 이름을 붙이게 됩니다. 2014년 초 하청이었던 신라젠은 본사인 제너렉스를 약 300원에 인수하고, 주주 중 한 명인 문은상을 대표로 세웁니다.

하지만 연구중인 펙사벡이 3상을 통과하게 되면 1200억 원을 더 주기로 되어있어 실상 1500억짜리 거래였다고 보면 됩니다. 투자금이 천억대다 보니 이철이라는 사람을 통해 투자회사를 만들어 약 7000억 원의 투자금을 만들게 됩니다.

이를 통해 이철은 450억 가량을 투자해 최대주주로 등극하게 되는데 이 사람은 철저한 노사모 회원이었습니다. 하지만 이철은 2018년에 사기혐의로 구속되고 징역 12년이 확정됩니다. 이때 이철의 번호인단은 민변 출신 변호사 5면으로 구성된 법무법인 향법입니다. 이정희, 심재환, 이재화 등인데 여기서 이정희는 다들 많이 아시는 그 통진당의 이정희입니다. 심재환은 이정희의 남편이고요.
또한 이철은 유시민이 창당한 국민참여당의 원외위원장을 맡은 적이 있습니다. 2015년에도 신라젠 항암기술 설명회에 유시민이 참석하여 직원들을 상대로 특강을 진행하기도 했었고요.

문재인 정부가 들어오면서 신라젠의 만 원짜리 주식이 15만 3천 원까지 폭등하며 코스닥 시총 2위까지 올라가는 기염을 토했는데요. 운영진은 10만 원대에서 아주 큰 이득을 보고 나가고 문은상 대표 역시 주식을 정리해 1300억 원의 이득을 봤습니다.

그리고 펙사벡은 미국 데이터 모니터링 위원회에서 임상 진행 중단을 권고받고 임상실험의 의미가 없을 정도의 효능이라고 공표됩니다. 이런저런 악재들이 겹쳐 고공행진을 하던 신라젠의 주가는 1만 원대로 폭락하면서 투자했던 개미들은 피눈물을 흘리게 됩니다.
현재 신라젠은 지난 5월 4일 장 마감 이후 거래정지가 된 상태입니다. 내달 초 한국거래소의 1차 판단이 나오는 가운데, 관건은 주요 후보물질인 펙사벡의 가치 입증이란 관측입니다.

신라젠은 현재 한국거래소 기업심사위원회 심의를 앞두고 향후 매출 등을 담은 경영개선계획서를 제출한 상태입니다. 신약개발이 관건인 만큼 펙사벡의 기술수출 가능성과 가치에 대한 논의가 벌어질 것으로 예상되는 가운데 기심 위는 다음 달 7일에 열릴 예정이라고 합니다.

이상 신라젠 사건에 대해서 알아보았는데요. 주주의 한 사람으로서 거래정지가 빨리 풀리고 정상적인 매매가 이루어지길 바래봅니다. 너무 낙심하지 마시고 희망을 잃지 마세요. 오늘도 파이팅하시고 건강 잘 챙기시길 바랍니다.
'경제' 카테고리의 다른 글
| 현금영수증 하는이유 발급시 좋은 점과 신청방법 (0) | 2020.08.20 |
|---|---|
| 주휴수당 계산법 (0) | 2020.08.17 |
| 신혼부부 희망타운 자격 분양시기 대출 조건 (0) | 2020.07.30 |
| 임대차 3법이란? (0) | 2020.07.29 |
| 실업수당 신청방법 (0) | 2020.07.28 |
댓글